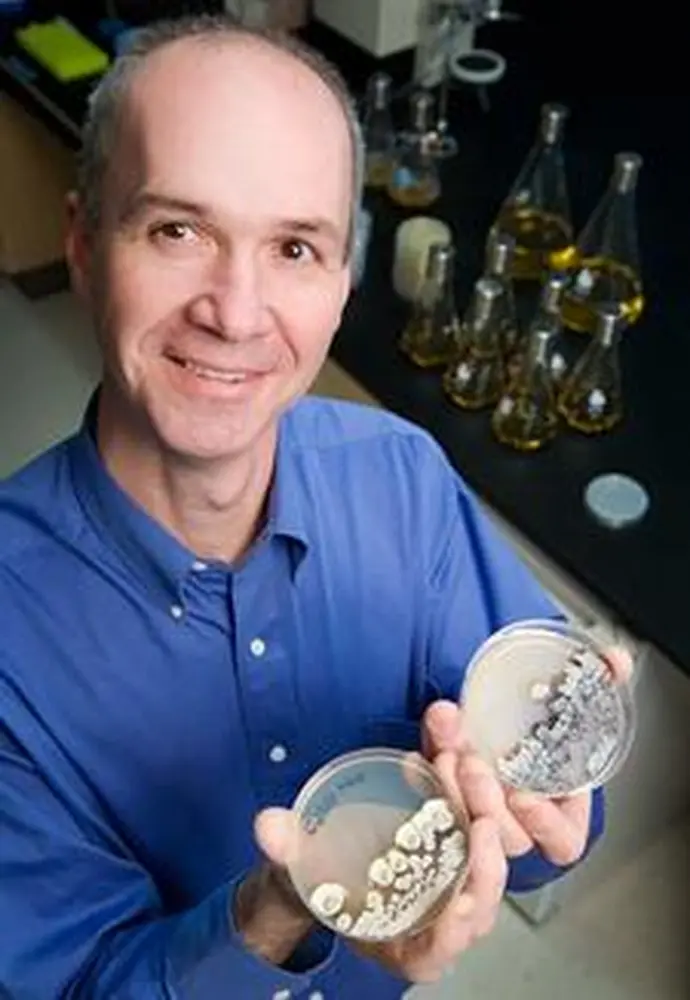

For every star in the universe, there are 1 billion bacteria here on earth. In the human body alone, you can find 10 times more bacterial cells than there are total human cells in the body.
“The number is so big that I can’t even wrap my mind around it,” says LAS microbiology professor William Metcalf, who has long been fascinated with the chemical warfare continuously taking place among bacteria. Now, he and his fellow University of Illinois researchers are looking for ways to tap into this chemical warfare and use it against a variety of medical threats, from malaria to cancer.
Ironically, about 70 percent of today’s antibiotics are created with the help of bacteria—a case of using bacteria to battle bacteria. The U of I team is tapping into the genetics that guide bacteria to create antibiotics from a little-known class of compounds called phosphonates. It’s all part of a $7 million, five-year effort to find medical uses for phosphonates.
“We may be living at the tail end of what some people call the Golden Age of Antibiotics,” Metcalf says. “The first medical uses for antibiotics were in the 1930s, so if you got tuberculosis before that time, they sent you to live in Arizona to live in the dry air. If you got strep throat, you would have a reasonable chance of getting rheumatic fever.”
Since the Age of Antibiotics began, however, people have grossly overused antibiotics, resulting in antibiotic-resistant strains. “And once bacteria have acquired resistance, they tend to hand it around to their friends,” he says.
Today, pharmaceutical companies are having a harder time finding new antibiotics to keep a step ahead of the bacteria, which is why Metcalf and his U of I colleagues are exploring the potential for using bacteria to create powerful new antibiotics from phosphonate compounds.
“But we aren’t looking for organisms that are actually making antibiotics,” Metcalf says. “We’re looking for organisms that have the capacity to make them.”
They begin the process by doing a genetic screening to identify the genes used to create a particular phosphonate compound. Then they genetically manipulate a bacterial organism to produce that compound at high levels.
For instance, Metcalf and his colleagues identified the processes by which bacteria create the anti-malarial phosphonate compound known as FR900098. His U of I colleague in chemical and biomolecular engineering, Huimin Zhao, is now engineering strains of the common E. coli bacterium to overproduce that compound.
In addition to Metcalf and Zhao, the research team includes Wilfred van der Donk and Neil Kelleher in chemistry, Satish Nair in biochemistry, and Jo Handelsman from the University of Wisconsin.
Metcalf’s work on phosphonates dates back to his graduate student days when he studied how bacteria broke down phosphonates in the soil. Among others, he looked at how bacteria broke down glyphosate, the well-known phosphonate herbicide popularly known as Roundup.
Out of this work, Metcalf had the idea that phosphonates could be a useful class of antibiotics. What’s more, they could have all sorts of medicinal uses beyond the ability to destroy bacteria. Phosphonates show potential as anti-cancer drugs, anti-viral drugs, and blood pressure medications, to name just a few other uses.
Phosphonates work by inhibiting various cellular processes, he explains. For instance, the FR900098 phosphonate inhibits the creation of isoprene, which bacteria need to survive, as does the parasite responsible for the most virulent form of malaria. Humans need isoprene as well, but this compound does not affect a person’s ability to synthesize it. Therefore, FR900098 targets certain bacteria and parasites, but not humans.
The U of I team has been perfecting a screening technique that has made it possible to find a “remarkably high percentage” of potentially useful phosphonate compounds. So far, he says they are finding about five compounds with antibiotic potential out of every 10 phosphonates they study. When pharmaceutical companies look for antibiotic compounds, they have to screen tens of thousands of strains to find just one.
“Nature has been conducting this experiment for 4 billion years,” Metcalf says. “If there’s a good target out there, I think it’s already been found by bacteria. We just have to tap into what nature has been doing already. We look to nature.”


